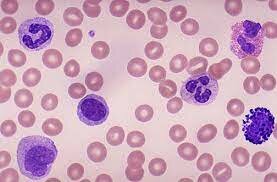
Anton van Leeuwenhoek

-
Egyptians first used bloodletting to try to cure diseases
-
The greeks discovered a difference between Arteries and Veins
-
First viewed blood cells under microscope
-
 First Blood transfusion performed
First Blood transfusion performed -
Discovered the 3 blood types (A, B, O)
-
 Discovered the 4th blood type; AB
Discovered the 4th blood type; AB -
Established the first blood donor service
-
Developed a method to store blood transfusions
-
Established the first blood bank
-
He discovered the Rh protein from the Rhesus monkey
-
First case of this was recorded in the Congo
-
Identified the virus that caused AIDS which is HIV
-
The development of this testing began
-
Scientists began screening for these
Looking for a timeline maker?
Create timelines for projects, roadmaps, history, lessons, legal cases, and stories with Timetoast. Timetoast is a timeline maker for work, school, research, and stories.